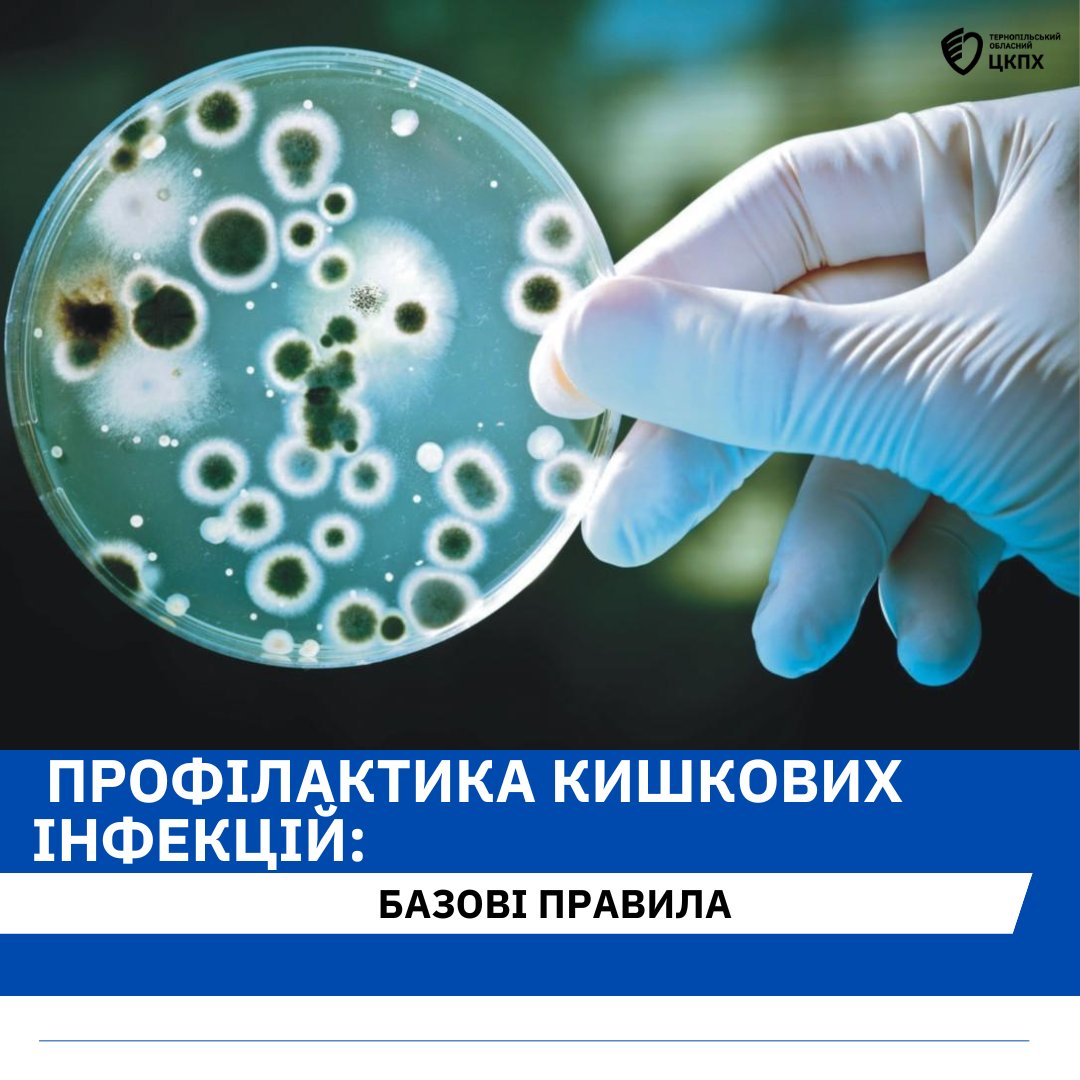

Профілактика кишкових інфекцій: базові правила
6 червня 2024Щоби уникнути гострих кишкових інфекцій, дотримуйтесь простих правил.
Особиста гігієна – понад усе
Ретельно мийте руки з милом перед вживанням їжі, після повернення з вулиці та після кожного відвідування туалету.
Чистота на кухні
– мийте та тримайте у чистоті всі поверхні та кухонні прилади, що використовуються для приготування їжі;
– користуйтеся індивідуальним посудом;
– не допускайте комах та тварин до приміщень, де готуєте їжу та зберігаються харчові продукти;
– регулярно мийте та обдавайте окропом дитячий посуд та іграшки.
Готування
– для обробки сирих продуктів використовуйте окремі кухонні прилади (ножі, дошки для готування тощо);
– окремо готуйте і зберігайте сирі та готові до вживання харчові продукти (сире м’ясо, птицю, рибу, овочі, фрукти тощо);
– добре проварюйте продукти, особливо м’ясо, птицю, яйця і рибу;
– використовуйте харчові продукти, оброблені з метою підвищення їх безпеки, наприклад, пастеризоване молоко;
– мийте та обдавайте окропом фрукти і овочі, особливо у разі споживання їх у сирому вигляді;
– не вживайте продукти з вичерпаним терміном придатності, використовувати для приготування їжі тільки свіжі харчові продукти;
– не давайте маленьким дітям некип’ячене розливне молоко, сирі яйця тощо.
Зберігання продуктів
– дотримуйтесь відповідного температурного режиму при зберіганні харчових продуктів (не залишайте приготовлені харчові продукти при кімнатній температурі більше ніж на 2 години);
– при транспортуванні і зберіганні харчових продуктів використовуйте чисту упаковку (поліетилен, контейнери для харчових продуктів тощо).
Чиста вода
– використовуйте безпечну воду, не пийте воду з неперевірених джерел;
– вживайте бутильовану воду або охолоджену кип’ячену воду;
– не купайтеся в непроточних водоймах, у місцях несанкціонованих пляжів, уникайте заковтування води під час купання.
Своєчасна медична допомога
При появі симптомів захворювання (підвищення температури тіла, біль голови, інтоксикація, блювання, рідкі випорожнення, біль у животі, висипання на шкірі тощо) треба одразу звертатись до лікаря. Самолікування може призвести до значних ускладнень.